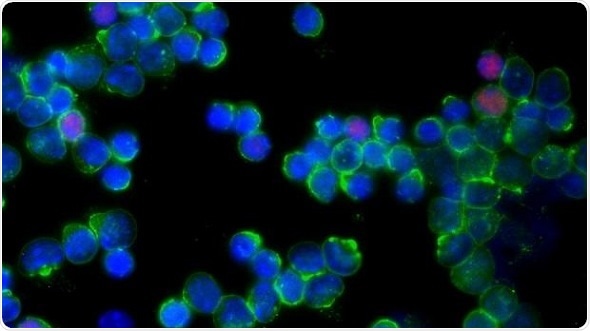
Cancer Research UK Convergence Science Centre announces tumor liquefying microbubbles

Scientists are re-imagining ultrasound technology to develop a treatment that can liquefy cancer cells in the body using microscopic bubbles – without the need for invasive surgery – as part of the new £13 million Cancer Research UK Convergence Science Centre at The Institute of Cancer Research and Imperial College London, announced today (Monday).
Tumor-promoting (pink) and tumor-suppressing (blue) immune cells being tracked using new technology
Cancer Research UK is bringing together scientists from two of the UK’s foremost academic research institutions under the leadership of renowned cancer experts, Professor Paul Workman from The Institute of Cancer Research, London, and Professor the Lord Ara Darzi from Imperial College London
Their shared vision for a center dedicated to convergence science integrates the knowledge, methods and expertise from different scientific disciplines – from physics to data science, and from engineering and the biological sciences to medicine. This will enable teams at the Centre to work together in completely new ways, to speed up scientific discovery and innovation for people with cancer and create new treatments and technologies.
In one project at the Centre, a team of biologists, physicists, engineers and clinicians are exploring whether a specialized therapeutic version of ultrasound, called histotripsy, could be adapted to destroy pancreatic tumors located deep within the body.
The team will use tightly focused, high-frequency sound waves to target and break apart cancer cells with the help of microbubbles. The sound waves cause the microbubbles to expand and contract rapidly, putting a strain on the cancer cell and breaking it apart into harmless fragments to be reabsorbed into the body and expelled through natural processes.
The researchers hope that by using this technology, the size of a tumor could be gradually reduced as they move the focal point of the sound waves around, like chipping away at it with a tiny hammer, until all cancerous tissue is destroyed.
In another project, researchers are fine-tuning a technique, originally developed to explore autoimmune diseases such as multiple sclerosis, to look at the activation of immune cells within a tumor in real-time.
Cancer experts and bioinformaticians are working together to investigate how the delicate balance between tumor-killing and tumor-promoting immune cells can tip as cancer evolves. It is hoped that this technology could be used to gain a better understanding of why immunotherapies work for some patients but not others.
Michelle Mitchell, chief executive of Cancer Research UK, said:
Although we are making great strides in the treatment of some cancers, survival remains stubbornly low for others, such as pancreatic cancer. If we are to make any real progress for patients, we need to take a bolder and more creative approach to research.
By opening new avenues for collaboration, we can bring in fresh ideas from outside the traditional cancer research space. This convergence will allow us to tackle research challenges from completely different angles, so we can scale the hurdles that have prevented treatment breakthroughs in the past, and secure a future for more people with cancer.”
Professor Paul Workman, Chief Executive of The Institute of Cancer Research, London, and Director of the Convergence Science Centre, said:
It’s fantastic to think that microbubbles could be used to blow cancer cells apart, and this is just one example of the exciting innovation we expect to see within the new Convergence Science Centre.
Our new Centre will be a coming together of world-class researchers in fields such as engineering, physics, chemistry and AI, collaborating closely with outstanding biologists and clinicians to create new solutions to the critical challenges we face in cancer research, diagnosis and treatment. It will open exciting new frontiers in cancer research and lead to innovative treatments, tests and technologies for patients.
With Cancer Research UK’s support, we have brought together two world-leading research organizations with complementary areas of expertise, building a vibrant collaborative culture that will nurture a new generation of truly multidisciplinary cancer researchers.”
Professor the Lord Ara Darzi, Director of Imperial College London’s Cancer Research Centre, said:
Through this new center and the training opportunities it presents, we will instil the importance of multidisciplinary collaboration into tomorrow’s researchers. Data science, physics and engineering are already transforming the way we treat cancer; integrating the expertise and knowledge of these disciplines is key to future-proofing our important work.
By creating a new generation of convergent scientists, we’re opening the door to new tools, devices and algorithms that we could never have imagined before. The combined strength of our two world leading institutions will set the standard for the future of convergence science, to transform cancer research in the UK and across the world.”
Rajesh Agrawal, Deputy Mayor for Business, said:
London is a world-leading center for life sciences with a rich ecosystem that has been at the very forefront of medical discovery and innovation for hundreds of years.
I am very pleased that we can now add the Cancer Research UK Convergence Science Centre to the list of groundbreaking scientific initiatives in the capital.